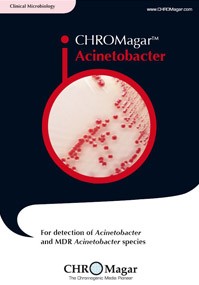
CHROMagar Acinetobacter
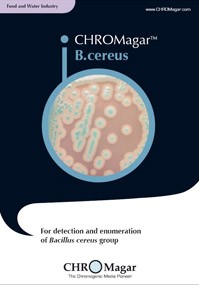
CHROMagar B.cereus
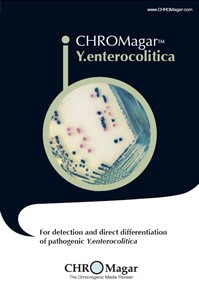
CHROMagar Y.enterocolitica
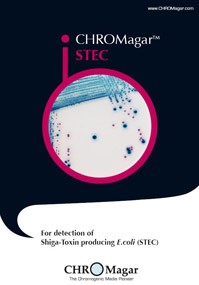
CHROMagar STEC

CHROMagar: Single-step, Chromogenic Testing Media for Colorful Microbial Detection
The Widest Range of Chromogenic Media Available on the Market
CHROMagar ™ supplies the widest range of chromogenic culture media available today
CHROMagar ™ covers applications in clinical bacteriology, industrial microbiology, quality control for food and beverage industries, water testing and environmental monitoring, among others. These media allow for a quicker and simpler detection of key clinical and food-borne pathogens, including Salmonella, Staph aureus, Candida albicans, E.coli O157, Group B Strep, E.coli, Listeria, Vibrio and Pseudomonas.
Research-driven and high-tech, CHROMagar ™ consists of a select team of highly-trained scientists and technicians led by its founder Dr. Rambach. A leader in the innovative field of chromogenic culture media technology, CHROMagar ™ is a commercially successful and growing enterprise with efficient international reach through its worldwide distribution network.
From pioneer research to cutting edge techniques, CHROMagar ™ leads the way in chromogenic media.
CHROMagar™ Microbiology was incorporated in 1993 by inventor, and pioneer in chromogenic media technology, Alain Rambach. Established in the heart of Paris (France), not far from the famous Pasteur Institute where Dr. Rambach began his research career, CHROMagar™ provides innovative chromogenic culture media solutions, designed to improve and simplify traditional culture techniques. CHROMagar™ is at the cutting edge of a diagnostic field that developed out of Dr. Rambach’s pioneering research in the late 1970’s.
30 years’ experience, specialization and know-how.
Innovation and research
Worldwide recognition and an international distribution network
Pseudomonas
5000 ml
PS832
Salmonella
SA132
Salmonella +
SA162
Staph aureus
TA672
mSuperCARBA™
SC172
Campylobacter
CP572
B.cereus
BC732
Y.enterocolitica
YE492
Enterobacteria
EB042
COL-APSE
CO262
C.perfringens
PF652
StrepA
SP372
B. Cepacia
5000 mL
BK992